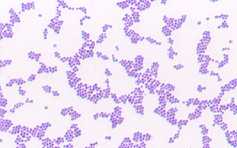

POLÍMEROS R AMIFICADOS DE ESTRUCTURA COMPLEJA
Forman parte de la pared celular de las Eubacterias. Según la estructura de la pared bacteriana, las eubacterias se clasifican en Gram-positivas y Gram-negativas, en función de que den positivo o no a un procedimiento de tinción desarrollado por el microbiólogo danés Gram (1853-1938).
|
Tipo de bacteria
|
Gram (+)
|
Gram(-)
|
|
Composición |
||
|
Aspecto de las bacterias al microscopio óptico |
|
 |
|
Aspecto de la pared celular al microscopio electrónico |
 |
 |




 Junto
a los peptidoglicanos, forman parte de la pared de bacterias Gram-positivas.
Son polímeros de N-acetilglucosamina,
un polialcohol y fosfato. El polialcohol (marcado en la figura
como alditol) puede ser glicerol o ribitol, y se une mediante enlaces éster
con el ácido fosfórico, formando una cadena lineal. Los hidroxilos libres
del polialcohol se unen covalentemente a monosacáridos simples o derivados,
o a D-aminoácidos. Los ácidos teicoicos se unen covalentemende
al ácido murámico y pueden así conectar diversas capas
de peptidoglicano.
Junto
a los peptidoglicanos, forman parte de la pared de bacterias Gram-positivas.
Son polímeros de N-acetilglucosamina,
un polialcohol y fosfato. El polialcohol (marcado en la figura
como alditol) puede ser glicerol o ribitol, y se une mediante enlaces éster
con el ácido fosfórico, formando una cadena lineal. Los hidroxilos libres
del polialcohol se unen covalentemente a monosacáridos simples o derivados,
o a D-aminoácidos. Los ácidos teicoicos se unen covalentemende
al ácido murámico y pueden así conectar diversas capas
de peptidoglicano.
